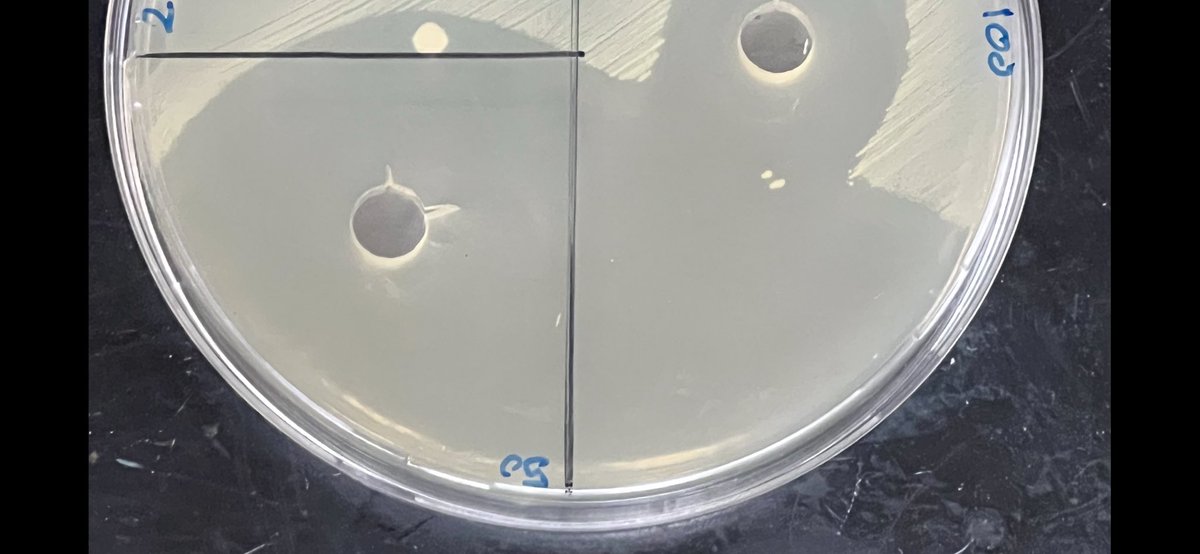
د. سلطان بن منصور الشريف tweet media

🇸🇦 زين سلامه | Zain Salamah
4.6K posts


🇸🇦 زين سلامه | Zain Salamah
@zain2help
اعمال خاصة











نجاح استثنائي لأمسية #دردشة_وسوالف_مهنية في مدينة المدينة المنورة🤩! بكل فخر واعتزاز، نختتم أمسيتنا لشهر ديسمبر 2025 ضمن فعاليات #أحياء_بلا_حدود #BioNoLimits شكر خاص لشريكنا الاستراتيجي @fekrhub لاستضافتهم امسياتنا نقدم جزيل الشكر لضيوفنا الكرام الذين أثروا الأمسية بحضورهم وخبراتهم القيمة، ونخص بالذكر: - أ. ريام الأحمدي " مؤسِس أول منصة عربية متخصصة بعلوم الفضاء " @reyamland - أ. عبدالعزيز الجهني " خبير في التطوير والتدريب المهني " - أ. كوثر فارس " اخصائية مختبرات طبية ومتخصصة في الجودة الصحية وال point of care testing " | @Koutherfaris - أ. جميل المدني "مهندس ورائد أعمال، والرئيس التنفيذي والمؤسس المشارك لعلامة جرعة يابانية، مهتم بالابتكار العلمي " | @jeme92 - أ. زين سلامه " مستشار موارد بشرية مرخص، اعلامي مرخص مهتم بصناعة القادة وتطوير الكفاءات " | @Zain2help - د. فايز الشهري " مؤثر متخصص ودكتوراه في علم الوراثة " | @Dr_Fayez_sh - أ. بندر الشهري " اخصائي تطبيقات لدى شركة سيمنس الصحية، مؤسس ورئيس مجلس ادارة جمعية بصمة لدعم الامراض الوراثية " | @07block07 - أ. طلال رحيم " مدير ومستشار في الموارد البشرية " | @talal_rahim - أ. محمد اسكوبي " مدير المختبر المتنقل في الأمانة " @mskobi2928 - د.نهلة الحضرمي " مسؤولة المختبرات البحثية المركزية في جامعة طيبة " | @dr_nolla - أ. أروى الشريف " مختبرات مصنع نستله " - د. ساره الذبياني " أستاذ علم الحيوان وعضو لجان الابتعاث والتدريب والدراسات العليا بجامعة طيبة " - د. نوادر القاضي " أستاذ مساعد كيمياء وخريجة علوم بيئية من كاوست " - أ. صفاء الفكي " مؤسسة معهد تدريب، مهتمة بتوظيف الذكاء الاصطناعي في تطوير التعليم " - أ. عبدالرحمن حسين " متخصص في الأحياء الدقيقة ومؤسس @biologistgroup “ | @d2a8h - أ. جهاد دين “ ماجستير ومهتم ومتخصص بمجالات الأغذية " | @JAD_din شكر خاص لفريق التغطية الإعلامية الذي أبدع في توثيق هذه اللحظات: أ. فاطمة محمد | @fatimah_cc9 أ. إيناس عبدالعزيز كما نوجه شكرنا وتقديرنا الكبيرين لشركاء النجاح، فبكم ومعكم ارتقت هذه الأمسية. نأمل أن تكون الأمسية قد فتحت لكم آفاقاً جديدة من الإلهام والفرص المهنية. ترقبوا البرومو الرسمي الكامل ولقاءات حصرية مع ضيوفنا الكرام... لقاؤنا يتجدد في أمسياتنا القادمة! 🙏






BREAKING NEWS The Royal Swedish Academy of Sciences has decided to award the 2025 #NobelPrize in Chemistry to Susumu Kitagawa, Richard Robson and Omar M. Yaghi “for the development of metal–organic frameworks.”